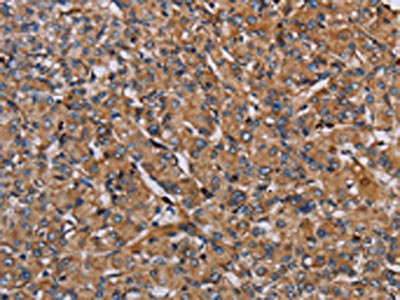
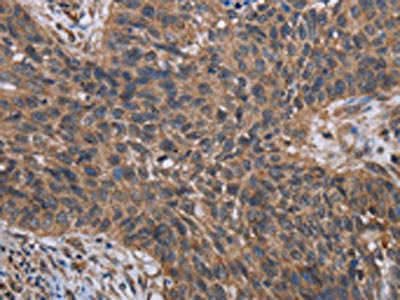

HIF1A Antibody
-
中文名稱:HIF1A兔多克隆抗體
-
貨號:CSB-PA968396
-
規格:¥1100
-
圖片:
-
The image on the left is immunohistochemistry of paraffin-embedded Human prostate cancer tissue using CSB-PA968396(HIF1A Antibody) at dilution 1/40, on the right is treated with fusion protein. (Original magnification: ×200)
-
The image on the left is immunohistochemistry of paraffin-embedded Human lung cancer tissue using CSB-PA968396(HIF1A Antibody) at dilution 1/40, on the right is treated with fusion protein. (Original magnification: ×200)
-
Gel: 8%SDS-PAGE, Lysate: 60 μg, Lane: Hela cells, Primary antibody: CSB-PA968396(HIF1A Antibody) at dilution 1/500, Secondary antibody: Goat anti rabbit IgG at 1/8000 dilution, Exposure time: 10 minutes
-
-
其他:
產品詳情
-
Uniprot No.:
-
基因名:
-
別名:ARNT interacting protein antibody; ARNT-interacting protein antibody; Basic helix loop helix PAS protein MOP1 antibody; Basic-helix-loop-helix-PAS protein MOP1 antibody; bHLHe78 antibody; Class E basic helix-loop-helix protein 78 antibody; HIF 1A antibody; HIF 1alpha antibody; HIF-1-alpha antibody; HIF-1alpha antibody; HIF-alpha antibody; HIF1 A antibody; HIF1 Alpha antibody; HIF1 antibody; HIF1-alpha antibody; HIF1A antibody; HIF1A_HUMAN antibody; hifla antibody; Hypoxia inducible factor 1 alpha antibody; Hypoxia inducible factor 1 alpha isoform I.3 antibody; Hypoxia inducible factor 1 alpha subunit antibody; Hypoxia inducible factor 1 alpha subunit basic helix loop helix transcription factor antibody; Hypoxia inducible factor 1; alpha subunit (basic helix loop helix transcription factor) antibody; Hypoxia inducible factor1alpha antibody; Hypoxia-inducible factor 1-alpha antibody; Member of PAS protein 1 antibody; Member of PAS superfamily 1 antibody; Member of the PAS Superfamily 1 antibody; MOP 1 antibody; MOP1 antibody; PAS domain-containing protein 8 antibody; PASD 8 antibody; PASD8 antibody
-
宿主:Rabbit
-
反應種屬:Human
-
免疫原:Fusion protein of Human HIF1A
-
免疫原種屬:Homo sapiens (Human)
-
標記方式:Non-conjugated
-
抗體亞型:IgG
-
純化方式:Antigen affinity purification
-
濃度:It differs from different batches. Please contact us to confirm it.
-
保存緩沖液:-20°C, pH7.4 PBS, 0.05% NaN3, 40% Glycerol
-
產品提供形式:Liquid
-
應用范圍:ELISA,WB,IHC
-
推薦稀釋比:
Application Recommended Dilution ELISA 1:1000-1:2000 WB 1:200-1:1000 IHC 1:50-1:200 -
Protocols:
-
儲存條件:Upon receipt, store at -20°C or -80°C. Avoid repeated freeze.
-
貨期:Basically, we can dispatch the products out in 1-3 working days after receiving your orders. Delivery time maybe differs from different purchasing way or location, please kindly consult your local distributors for specific delivery time.
-
用途:For Research Use Only. Not for use in diagnostic or therapeutic procedures.
相關產品
靶點詳情
-
功能:Functions as a master transcriptional regulator of the adaptive response to hypoxia. Under hypoxic conditions, activates the transcription of over 40 genes, including erythropoietin, glucose transporters, glycolytic enzymes, vascular endothelial growth factor, HILPDA, and other genes whose protein products increase oxygen delivery or facilitate metabolic adaptation to hypoxia. Plays an essential role in embryonic vascularization, tumor angiogenesis and pathophysiology of ischemic disease. Heterodimerizes with ARNT; heterodimer binds to core DNA sequence 5'-TACGTG-3' within the hypoxia response element (HRE) of target gene promoters. Activation requires recruitment of transcriptional coactivators such as CREBBP and EP300. Activity is enhanced by interaction with NCOA1 and/or NCOA2. Interaction with redox regulatory protein APEX1 seems to activate CTAD and potentiates activation by NCOA1 and CREBBP. Involved in the axonal distribution and transport of mitochondria in neurons during hypoxia.; (Microbial infection) Upon infection by human coronavirus SARS-CoV-2, is required for induction of glycolysis in monocytes and the consequent proinflammatory state. In monocytes, induces expression of ACE2 and cytokines such as IL1B, TNF, IL6, and interferons. Promotes human coronavirus SARS-CoV-2 replication and monocyte inflammatory response.
-
基因功能參考文獻:
- These findings demonstrated a valuable antitumor synergism in combining CRISPR/Cas9mediated HIF1alpha knockout with Transarterial embolization (TAE)in mice and highlighted the possibility that HIF1a may be an effective therapeutic knockout target in combination with TAE for hepatocellular carcinoma treatment PMID: 30226584
- Since the FIH-1 dependent hydroxylation of NAA10 occurs oxygen-dependently, NAA10 acetylates HIF-1alpha under normoxia but does not under hypoxia. PMID: 30237125
- HIF1A is upregulated in breast and bladder tumors with high NRF2 activity. NRF2 targets a functional antioxidant response element at the HIF1A locus, which reveals a direct regulatory connection between two important oxygen responsive transcription factors. PMID: 30241031
- CPT1A is repressed by HIF1 and HIF2, reducing fatty acid transport into the mitochondria, and forcing fatty acids to lipid droplets for storage. PMID: 29176561
- MiR-497 approximately 195 cluster regulates angiogenesis during coupling with osteogenesis by maintaining endothelial Notch1 and HIF1A activity. PMID: 28685750
- Study revealed that HIF1alpha was significantly upregulated in gallbladder cancer (GBC) tissues. HIF1alpha overexpression was closely associated with lymph node metastasis and TNM stage. HIF1alpha was able to promote cell migration in a hypoxic microenvironment by overexpressing VEGF in GBC cell line. PMID: 30272364
- HIF-1alpha "positive" had decreased overall survival compared to HIF-1alpha "negative" patients and this was an independent adverse prognostic factor for HCC patients with cirrhosis, but not for cirrhosis-free patients. PMID: 30274686
- genetic polymorphisms in HIF1A were not associated with persistent apical periodontitis PMID: 29898065
- Hypoxia-induced angiogenesis is a complex process that involves distinct but also overlapping functions of HIF-1alpha and HIF- 2alpha in regard to angiogenesis, bioenergetic adaption and the redundant transcriptional induction of MIF. PMID: 28993199
- High HIF1A expression is associated with high Collagen I Fibers in Triple Negative Breast Cancer. PMID: 29247885
- Cathepsin B (CTSB) is a novel target gene of hypoxia-inducible factor-1-alpha (HIF-1alpha). CTSB mRNA and protein levels can be up-regulated in a HIF-1alpha-dependent manner. PMID: 29935187
- this is the first case-control study uncovering that the HIF1A gene rs10873142 polymorphism increases the risk of COPD in a Chinese Han population. PMID: 29339421
- ST6Gal-I activity augmented HIF-1alpha accumulation in cells grown in a hypoxic environment or treated with two chemical hypoxia mimetics, deferoxamine and dimethyloxalylglycine. PMID: 29475939
- mRNA expression levels of both HIF1A and LACC1 were upregulated in the skin lesions of individuals with leprosy. PMID: 29706348
- data suggest an important role of miR-210 in sustaining HIF-1alpha activity via the suppression of HIF-3alpha, regulating cell growth and chemotherapeutic drug resistance in cholangiocarcinoma. PMID: 29953500
- HOXA9 inhibits HIF1A-mediated glycolysis through interacting with CRIP2 to repress cutaneous squamous cell carcinoma development. PMID: 29662084
- HIF-1alpha inhibits NCR1/NKp46 pathway through up-regulating miR-224, which affects the killing capability of NK cells on prostate cancer, thus inducing immune escape of tumor cells. PMID: 29885835
- The findings demonstrate that AGPAT2, which is mutated in patients with congenital generalized lipodystrophy and over-expressed in different types of cancer, is a direct transcriptional target of HIF-1, suggesting that upregulation of lipid storage by HIF-1 plays an important role in adaptation and survival of cancer cells under low oxygen conditions. PMID: 29908837
- Overexpression of HIF1A leads to radioresistance of cervical cancer. PMID: 30355300
- Knockdown of DEC2 resulted in a significant (26.7%) reduction of VEGF expression in MIO-M1 cells under hypoxia-mimicking conditions induced by DFO (P < .05). Levels of HIF1alpha protein were also reduced significantly, by 60.2%, in MIO-M1 cells treated with siRNA against the DEC2 gene (P < .05). Moreover, HIF1alpha levels showed a significant (2.5-fold) increase in MIO-M1 cells overexpressing DEC2 (P < .05). PMID: 30250985
- High HIF1A expression is associated with salivary adenoid cystic carcinoma. PMID: 30015895
- we found that Hif-1alpha directly promoted H19 expression through binding to the H19 promoter and indirectly through SP1-mediated H19 transcriptional activation under hypoxia in glioblastoma cells. PMID: 28327666
- The IRIS-driven metastatic mechanism results from IRIS-dependent suppression of phosphatase and tensin homolog (PTEN) transcription, which in turn perturbs the PI3K/AKT/GSK-3beta pathway leading to prolyl hydroxylase-independent HIF-1alpha stabilization and activation in a normoxic environment. PMID: 30254159
- Data show that von Hippel-Lindau-binding protein 1 (VBP1) enhances the stability of von Hippel-Lindau tumor suppressor protein (pVHL) and facilitates pVHL-mediated ubiquitination of hypoxia-inducible factor 1, alpha subunit (HIF-1alpha). PMID: 29121446
- Multifunctional proteins epigenetically modulating HIF1A stability and activity have been described. (Review) PMID: 29032501
- Studies have shown that both HIF1alpha and HIF2alpha may contribute to the regulation of cellular adaptation to hypoxia and resistance to cancer therapies with their potential to exert significant effects on the maintenance and evolution of cancer stem cells. Also, HIF1alpha and HIF2alpha seemed to have significant prognostic and predictive value. [review] PMID: 29845228
- HIF-1 was overexpressed in osteosarcoma tissues and cell lines, which promoted cell proliferation, clone formation, migration, invasion and inhibited cell apoptosis. PMID: 29807229
- hypoxiainduced expression of CXCR4 promoted trophoblast cell migration and invasion via the activation of HIF1alpha, which is crucial during placentation. PMID: 29786753
- Data suggest that NRF2/NFE2L2 promotes breast cancer progression by enhancing glycolysis through co-activation of HIF1A; NRF2 and HIF1A mRNA and protein levels are significantly up-regulated in breast cancer cells as compared to benign breast epithelial cells. (NRF2/NFE2L2 = nuclear factor erythroid 2-related factor 2; HIF1A = hypoxia inducible factor 1 subunit alpha) PMID: 29275212
- the expression of MMIF, HIF-1alpha, and VEGF in the serum and endometrial tissues may be used to assess the stage of endometriosis and the severity of dysmenorrhea. PMID: 30074218
- Findings revealed an HIF-1alpha/IL-1beta signaling loop between cancer cells and tumor-associated macrophages in a hypoxic microenvironment, resulting in cancer cell epithelial-mesenchymal transition and metastasis; more importantly, our results suggest a potential role of an anti-inflammatory strategy in hepatocellular carcinoma treatment PMID: 29171040
- Overexpression of HIF-1alpha and P4HB is associated with poor prognosis in patients with gastric cancer. PMID: 29904245
- hypoxic stress in the hepatocellular carcinoma (HCC)cells promoted YAP binding to HIF-1a in the nucleus and sustained HIF-1a protein stability to bind to PKM2 gene and directly activates PKM2 transcription to accelerate glycolysis PMID: 30180863
- Overexpression of VHL was more successful at inhibiting fibrosis compared with silencing HIF-1a plus HIF-2a. Normoxia-active HIF-1a or HIF-2a prevented the inhibitory effect of VHL on liver fibrosis, indicating that attenuating fibrosis via VHL is HIF-1a- and HIF-2a-dependent to some extent. PMID: 28112200
- Results find that knockdown of HIF-1alpha reduced hypoxia-induced SENP1 expression, suggesting that induction of SENP1 expression is mediated by hypoxia-inducible factor HIF-1alpha. PMID: 28796315
- ADM was an upstream molecule of HIF-1alpha/VEGF and it promoted angiogenesis through upregulating HIF-1alpha/VEGF in epithelial ovarian cancer. PMID: 28091613
- HIF-1alpha expression correlates with the expression level of IL- 8, as evidenced by the down regulation of IL-8 in response to silencing of HIF-1alpha in HCC cell lines under hypoxic conditions. PMID: 29881400
- MOLP8/R cells display a very high overexpression of LCP1 gene (l-Plastin) controlled by HIF1&alpha. PMID: 29882856
- the role of FTH1 in the FIH control of HIF-1 activity, is reported. PMID: 29580991
- The findings of the current study demonstrate presence of the IDH1 R132H mutation in primary human glioblastoma cell lines with upregulated HIF-1alpha expression, downregulating c-MYC activity and resulting in a consequential decrease in miR-20a, which is responsible for cell proliferation and resistance to standard temozolomide treatment. PMID: 29625108
- The cross-talk between HIF1A, NRF2 and NF-kappaB is required to adapt to changes in oxygen availability. (Review) PMID: 29485192
- PKD1 not only regulates the hypoxic glycolytic metabolism of cancer cells via regulation of the expression of HIF-1alpha and glycolytic enzymes. PMID: 29901206
- Results provide evidence that HIF1alpha overexpression promotes the radioresistance of prostate cancer cells through enhanced betacatenin nuclear translocation. PMID: 29658569
- Collectively, the present study demonstrated mitochondrial fission as a tumor suppression process that is regulated by the HIF/miR125a/Mfn2 pathways, acting to restrict PANC1 cell survival, energy metabolism and migration, with potential implications for novel approaches for PC therapy. PMID: 29749475
- the results of the present study demonstrated that hypoxia-induced cytoprotective autophagy counteracted gemcitabine-induced apoptosis through increasing HIF1alpha expression PMID: 29693166
- CD40 is a key molecule for the upregulation of HIF-1alpha and PTEN underlying the severity of microangiopathy. PMID: 29549140
- Enhanced expression of HIF-1alpha may be related to autophagy activation in SH-SY5Y cells, thus contributing to ischemic/hypoxic brain damage. PMID: 29724989
- Data show that deletion of hypoxia inducible factor 1 subunit alpha (HIF-1alpha) in NK cells inhibited tumour growth despite impaired tumour cell killing. PMID: 29150606
- AEG-1 was found to be significantly associated with hypoxia in ovarian cancer by regulating the HIF-1alpha/NF-kappaB/VEGF pathway. PMID: 29770329
- no significant differences in the serum levels between early-onset pre-eclampsia, late-onset pre-eclampsia, and controls PMID: 28574293
顯示更多
收起更多
-
亞細胞定位:Cytoplasm. Nucleus. Nucleus speckle.
-
組織特異性:Expressed in most tissues with highest levels in kidney and heart. Overexpressed in the majority of common human cancers and their metastases, due to the presence of intratumoral hypoxia and as a result of mutations in genes encoding oncoproteins and tumo
-
數據庫鏈接:
Most popular with customers
-
-
YWHAB Recombinant Monoclonal Antibody
Applications: ELISA, WB, IHC, IF, FC
Species Reactivity: Human, Mouse, Rat
-
-
-
-
-
-